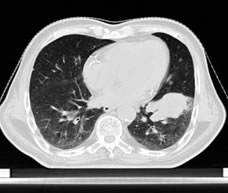

放射治疗在恶性肿瘤治疗中起什么作用?
在癌症患者的治疗过程中,大约70%的病人需要进行放射治疗,据世界卫生组织统计大约有18%的肿瘤可以用放疗根治。有些早期肿瘤单用放疗治愈率很高,如早期食管癌,宫颈癌,声带癌,霍奇金淋巴瘤,皮肤癌等。早期食管癌,前列腺癌,舌癌等5年生存率都与手术相似,而且美容效果较满意。一般来医院就诊的肿瘤患者中,70%~80%属中晚期患者,多数病人不能手术,或手术切除困难,或有手术禁忌,需行放射治疗,而且不少患者疗效较好。近年来,采用立体定向放疗,或调强治疗不能手术的早期非小细胞肺癌、肝癌、胰腺癌及转移癌等获得与外科手术相似的结果,为很多不能手术的早期肿瘤的根治开辟了新途径。放射治疗在肿瘤综合治疗中亦占有重要的地位,如与外科配合的术前、术中和术后放疗;与化疗配合的化疗前、中及化疗后放疗;还有放疗,手术和化疗三者配合的综合治疗。总之放射治疗是大多数恶性肿瘤患者不可或缺的重要治疗手段。恶性肿瘤病人应及时到放疗科会诊和诊治。

放射治疗的优点有哪些?
·适用范围广,几乎可以用于全身各部位的肿瘤;
·对接受治疗的病人自身条件要求不高,因年龄大、体质差、已行多次手术等原因不能耐受其它疗法治疗的病人,也可接受放射治疗;
·治疗效果确实、治疗方法可靠,可单独应用,也可与手术、化疗联合应用;治疗过程简单,治疗时无痛苦,不需住院治疗,易被病人接受;
·治疗副作用相对较少,可避免手术造成的麻醉意外、输血反应、术后感染及化疗造成的脱发、呕吐等副反应;
放射疗法为非创伤性治疗,早期肿瘤的单纯根治放疗在消灭肿瘤的同时,可保留器官的生理功能;术前放疗,可在不影响手术的前提下提高手术的切除率,可在不影响治疗效果的前提下提高器官生理功能保存率;术后放疗,可提高生存率,降低局部复发率。
左肺下叶肺癌

放疗前放疗后















